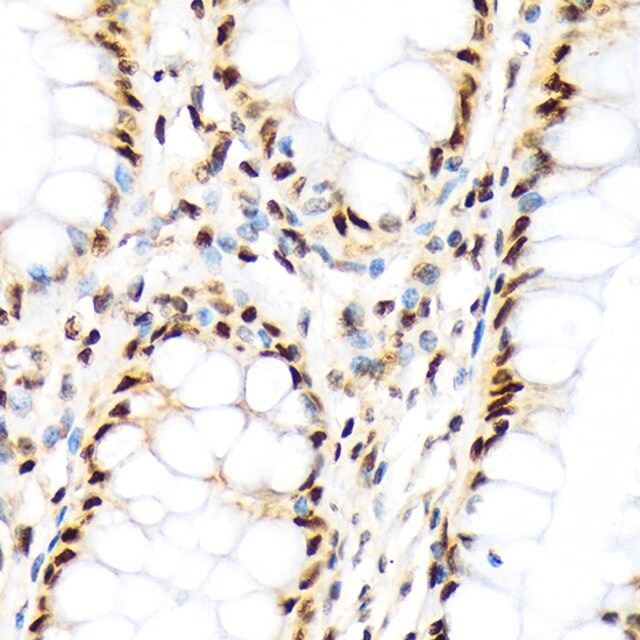

您的位置:首页 > 产品中心 > Anti-Histone H3 antibody produced in rabbit
产品性质
| biological source【生物来源】 | rabbit |
| Quality Level【质量水平】 | 100 |
| antibody product type | primary antibodies |
| clone【克隆】 | monoclonal |
| form【形式】 | liquid |
| concentration【浓度】 | 1 mg/mL |
| technique(s) | western blot: 1:500-1:2000 |
| UniProt accession no.【UniProt登记号】 | P68431 |
| shipped in【运输】 | wet ice |
| storage temp.【储存温度】 | −20℃ |
| Gene Information | human ... HIST1H3A(8350) |
基本信息
| General description【一般描述】 | Histones are basic nuclear proteins that are responsible for the nucleosome structure of the chromosomal fiber in eukaryotes. This structure consists of approximately 146 bp of DNA wrapped around a nucleosome, an octamer composed of pairs of each of the four core histones (H2A, H2B, H3, and H4). The chromatin fiber is further compacted through the interaction of a linker histone, H1, with the DNA between the nucleosomes to form higher order chromatin structures. This gene is intronless and encodes a replication-dependent histone that is a member of the histone H3 family. Transcripts from this gene lack polyA tails; instead, they contain a palindromic termination element. This gene is found in the large histone gene cluster on chromosome 6p22-p21.3. |
| Immunogen【免疫原】 | A synthesized peptide derived from human Histone H3 |
| Physical form【外形】 | Buffer: PBS with 0.02% sodium azide,0.05% BSA,50% glycerol,pH7.3. |